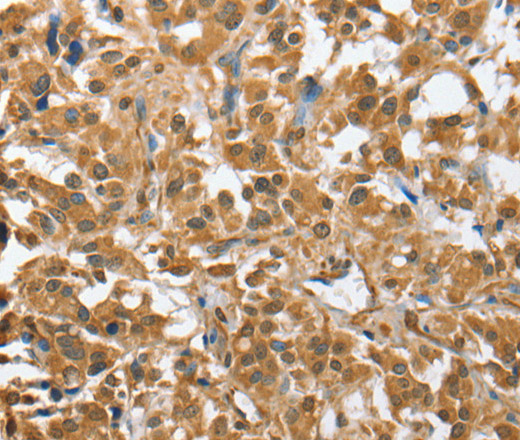
Валидация Elabscience E-AB-14871

| UNIPROT | Q9H444 |
| Иммуноген | Рекомбинантный белок, соответствующий человеческому CHMP4B |
CHMP4B Polyclonal Antibody (E-AB-14871)
Реактивность подтвержденная:
человек, мышь
Источник (хозяин):
кролик
Валидировано для:
IHC
Характеристики
Техническое описание
| Каталожный номер | E-AB-14871 |
| Название антигена | Chromatin Modifying Protein 4B (CHMP4B) |
| UNIPROT | Q9H444 |
| Иммуноген | Рекомбинантный белок, соответствующий человеческому CHMP4B |
| Английские синонимы | SNF7-2, Shax1, VPS32B, Charged Multivesicular Body Protein 4b, Putative charged multivesicular body protein 4B-like protein CHMP4BP1 |
Реактивность подтвержденная Нужна другая реактивность? |
человек, мышь |
| Источник (хозяин) | кролик |
| Изотип | IgG |
| Клональность | поликлональное |
| Рекомбинантное | нет |
| Готовое к использованию | нет |
| Концентрация | 0.3 мг/мл |
| Конъюгат | нет |
| Валидировано для | IHC Иммуногистохимия |
| Рекомендуемые разведения | IHC 1:50-1:200 |
| Метод очистки | Аффинная хроматография |
| Состав буфера | PBS с 0.05% азид натрия и 50% глицерин, PH7.4 |
| RRID | AB_535012 |
| Условия доставки | термобокс с аккумуляторами холода |
| Условия хранения | Хранить при -20°C - 12 месяцев. Избегать повторяющихся циклов замораживания/оттаивания |
| Срок хранения | 12 месяцев |
| Производитель | Elabscience |
| Ссылка на страницу товара на сайте производителя | https://www.elabscience.com/p-chmp4b_polyclonal_antibody-e_ab_14871 |
|
Артикул
|
Наименование |
Производитель
|
|---|
Акции и предложения
Популярные продукты:
Anti-CADM1/SynCAM1 Polyclonal Antibody (PHN06201)
Источник (хозяин): кролик
Реактивность подтвержденная: человек, мышь
Валидировано для: ELISA, IF, IHC, WB
Реактивность подтвержденная: человек, мышь
Валидировано для: ELISA, IF, IHC, WB
ELISA Kit DIY Materials for Dystrophin (DMD) (KSB503Hu01)
Организм: человек
Диапазон определения: 0.156-10 нг/мл
Чувствительность: 0.059 нг/мл
Диапазон определения: 0.156-10 нг/мл
Чувствительность: 0.059 нг/мл
Chicken AP 1 complex subunit sigma 2(AP1S2) ELISA kit (E12A1560)
Организм: курица
Human Anoctamin 3(ANO3) ELISA kit (E01A1529)
Организм: человек
Диапазон определения: 0.5-10 нг/мл
Чувствительность: 0.1 нг/мл
Диапазон определения: 0.5-10 нг/мл
Чувствительность: 0.1 нг/мл
Mouse vitamin B3 ELISA kit (E03V0421)
Организм: мышь
Sheep Tissue Polypeptide Antigen ELISA kit (E14T0013)
Организм: овца